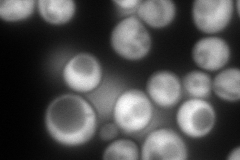
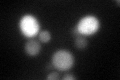
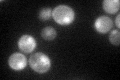

View description
Stress inducible cytoplasmic thioredoxin peroxidase; cooperates with Tsa1p in the removal of reactive oxygen, nitrogen and sulfur species using thioredoxin as hydrogen donor; deletion enhances the mutator phenotype of tsa1 mutants
Localization:
Intensity:
Fold change:
Significance:
-
C’ GFP library in SD

cytosol32.67 -
N' NOP1pr-GFP in SD
cytosol321.27 -
N' TEF2pr-mCherry in SD

cytosol127.564 -
N' NATIVEpr-GFP in SD

cytosol47.1059 -
N' TEF2pr-VC and Cyto-VN in SD

cytosol74.6354 -
C’ GFP library in SD+DTT
cytosol51.061.56Yes -
C’ GFP library in SD+H2O2

cytosol140.024.28Yes -
C’ GFP library in Starvation Media
nucleusN/AN/AYes -
C’ GFP library on the background of Pup2-DaMP

cytosol -
C’ GFP library on the background of CCT mutant

cytosol28.13630.861016No
